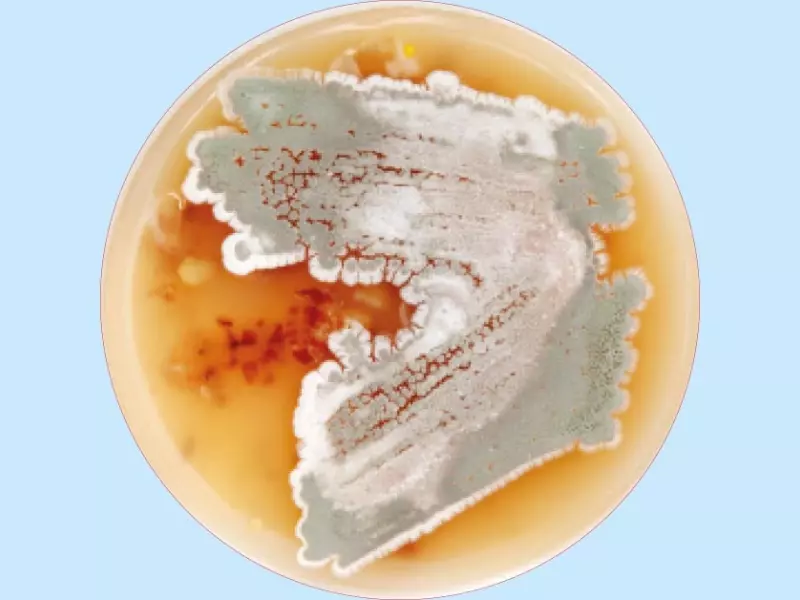

Niewiedza o tym gatunku wśród Polaków jest zdumiewająca. O ile chyba nie ma nikogo, kto nie kojarzyłby naszego poczciwego wiejskiego „boćka” białego, to świadomość, że w polskich borach i lasach żyje jego czarny kuzyn, jest domeną niewielu osób. Poza przyrodnikami (przede wszystkim ornitologami), wiedzę o istnieniu tego gatunku posiadają jeszcze leśnicy, myśliwi i wędkarze oraz niektórzy nauczyciele i urzędnicy. Brak świadomości u ogółu Polaków o istnieniu bociana leśnego, to wina decydentów odpowiedzialnych za program nauki przyrody już na poziomie szkoły podstawowej.
POLECAMY
Bocian czarny (Ciconia nigra) jest jednym z dwóch gatunków bocianów gniazdujących w Europie. Od bociana białego (Ciconia ciconia), różni się dominującą czernią upierzenia – u bociana czarnego jedynie brzuch i boki są białe. Czarne upierzenie osobników dorosłych mieni się metalicznym połyskiem, natomiast młode ptaki są matowo ciemnobrunatne. Dorosły bocian czarny posiada intensywnie czerwony dziób i nogi, natomiast ptak młody ma dziób i nogi oliwkowo-brązowe. Bardzo charakterystycznie wygląda pisklę bociana czarnego w pierwszych tygodniach życia – przypomina ono „puchatą” dziecięcą maskotkę, ponieważ pokrywa je biały puch, a krótki, masywny „dziobek” ma kolor żółty.
Wielkością bociany czarne minimalnie ustępuje „boćkom” białym: dorosłe mierzą ok. 90–105 cm długości (od dzioba do ogona), a rozpiętość ich skrzydeł sięga 175–205 cm. Dorosłe ptaki ważą ok. 3 kg.
Olbrzymi zasięg
Aktualny areał lęgowy bociana czarnego obejmuje większość obszaru Europy i umiarkowanej części Azji oraz południe Afryki.
Na naszym kontynencie skrajnie zachodnie stanowiska lęgowe, znajdują się w Portugalii i Hiszpanii, a wschodnie w górach Ural (pogranicze europejskiej i azjatyckiej części Federacji Rosyjskiej). Na północ sięga do Estonii oraz Rosji w rejonie Petersburga i Wołogdy. Z kolei najdalej na południu, gniazduje w lasach górskich Grecji i południa Włoch – w Kalabrii.
W Azji jego areał sięga od gór Ural na zachodzie, po wybrzeże Oceanu Spokojnego w rejonie ujścia rzeki Amur, na północ dochodząc w syberyjskiej tajdze do 60o szerokości północnej na obszarze dorzecza Obu i Leny, a na południu gniazduje w Turcji, północnym Iranie i Pakistanie oraz wschodnich Chinach.
W Afryce areał lęgowy bociana czarnego obejmuje południe kontynentu, od Namibii na zachodzie, po Mozambik na wschodzie, na północ sięgając do Zambii i Malawi.
Tradycyjne zimowiska bociana czarnego obejmują w Afryce strefę sawann i stepów, od Senegalu po Etiopię oraz wzdłuż Nilu od Egiptu po Ugandę, a także południe kontynentu – od Angoli i Tanzanii po RPA.
W Azji tradycyjne zimow...
Pozostałe 90% treści dostępne jest tylko dla Prenumeratorów
- 6 wydań czasopisma "Biologia w Szkole"
- Dostęp do wszystkich archiwalnych artykułów w wersji online
- ...i wiele więcej!